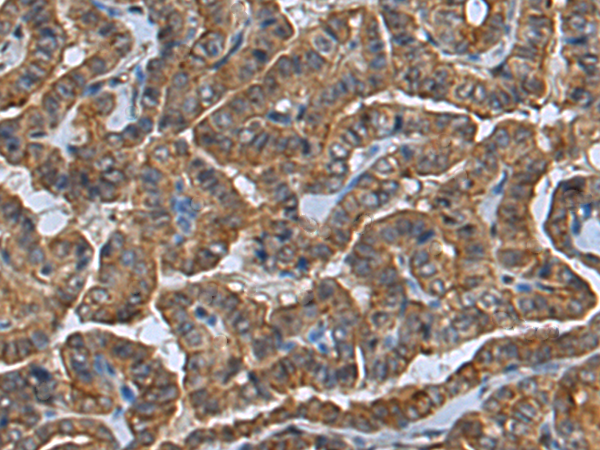
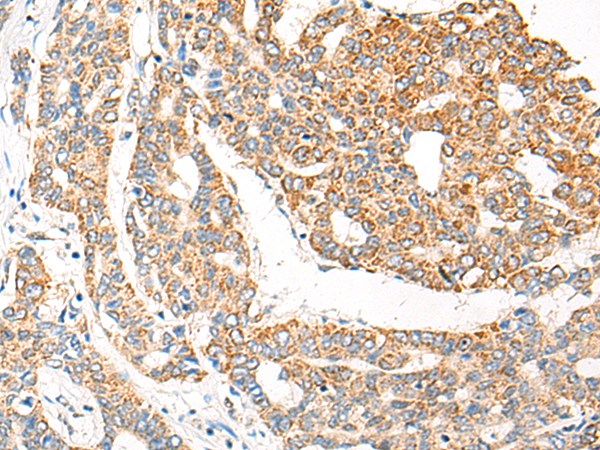

-
分类: 科研抗体货号: P09512别名: NAIC; CIRH1A; CIRHIN; TEX292应用: WB,IHC反应种属: Human, Mouse
-
分类: 科研抗体货号: P09505别名: YCL1; CHARC1; CHARC15; CHRAC-1; CHRAC15; CHRAC-15应用: IHC反应种属: Human
-
分类: 科研抗体货号: P09520别名: CLCNL2; CLIC2b; MRXS32; XAP121应用: IHC反应种属: Human, Rat
-
分类: 科研抗体货号: P09542别名: CAR; CAR1; MB67应用: IHC反应种属: Human
-
分类: 科研抗体货号: P09503别名: Vps60; CGI-34; PNAS-2; C9orf83; HSPC177; SNF7DC2应用: IHC反应种属: Human, Mouse, Rat
-
分类: 科研抗体货号: P09519别名: HOD; CLC7; CLC-7; OPTA2; OPTB4; PPP1R63应用: WB,IHC反应种属: Human, Mouse, Rat
-
分类: 科研抗体货号: P09540别名: MURR1; C2orf5应用: WB,IHC反应种属: Human, Mouse
-
分类: 科研抗体货号: P09502别名: DMT1; ALS17; VPS2B; VPS2-2; CHMP2.5应用: IHC反应种属: Human, Mouse
-
分类: 科研抗体货号: P09518别名:应用: IHC反应种属: Human, Mouse, Rat
-
分类: 科研抗体货号: P09539别名: MED; EDM6; STL4; DJ149L1.1.2应用: IHC反应种属: Human

鄂公网安备42018502007531号
鄂公网安备42018502007531号

